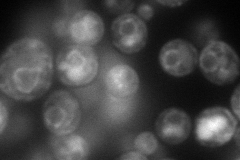
YBR162C
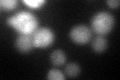
YBR162C

View description
Covalently-bound cell wall protein of unknown function; identified as a cell cycle regulated SBF target gene; deletion mutants are highly resistant to treatment with beta-1,3-glucanase; has sequence similarity to YJL171C
Localization:
Intensity:
Fold change:
Significance:
-
C’ GFP library in SD

vacuole34.45 -
N' NOP1pr-GFP in SD
cell periphery,ER,vacuole129.854 -
N' TEF2pr-mCherry in SD

cell periphery,vacuole58.7854 -
N' NATIVEpr-GFP in SD

cytosol126.699 -
N' TEF2pr-VC and Cyto-VN in SD

#N/A0 -
C’ GFP library in SD+DTT
vacuole39.251.13No -
C’ GFP library in SD+H2O2

vacuole30.20.87No -
C’ GFP library in Starvation Media

vacuole21.350.61Yes -
C’ GFP library on the background of Pup2-DaMP

vacuole -
C’ GFP library on the background of CCT mutant

vacuole32.32010.937889No
